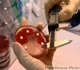

Redwap Hd sex, redwap indian, red wap india, categorise hd videos, Selected categories ,hd desi clips, hd mp4 sex
/The-Complete-Sex-Guide-(Sex-Education)/MP4-Videos
/MP4-Videos/The-Complete-Sex-Guide---Part-1.mp4)
|
The-Complete-Sex-Guide---Part-1
Size: 31912 KB
Views: 1815
|
/MP4-Videos/The-Complete-Sex-Guide---Part-10.mp4)
|
The-Complete-Sex-Guide---Part-10
Size: 31912 KB
Views: 1815
|
/MP4-Videos/The-Complete-Sex-Guide---Part-11.mp4)
|
The-Complete-Sex-Guide---Part-11
Size: 31912 KB
Views: 1815
|
/MP4-Videos/The-Complete-Sex-Guide---Part-12.mp4)
|
The-Complete-Sex-Guide---Part-12
Size: 31912 KB
Views: 1815
|
/MP4-Videos/The-Complete-Sex-Guide---Part-13.mp4)
|
The-Complete-Sex-Guide---Part-13
Size: 31912 KB
Views: 1815
|
/MP4-Videos/The-Complete-Sex-Guide---Part-14.mp4)
|
The-Complete-Sex-Guide---Part-14
Size: 31912 KB
Views: 1815
|
/MP4-Videos/The-Complete-Sex-Guide---Part-15.mp4)
|
The-Complete-Sex-Guide---Part-15
Size: 31912 KB
Views: 1815
|
/MP4-Videos/The-Complete-Sex-Guide---Part-16.mp4)
|
The-Complete-Sex-Guide---Part-16
Size: 31912 KB
Views: 1815
|
/MP4-Videos/The-Complete-Sex-Guide---Part-17.mp4)
|
The-Complete-Sex-Guide---Part-17
Size: 31912 KB
Views: 1815
|
/MP4-Videos/The-Complete-Sex-Guide---Part-18.mp4)
|
The-Complete-Sex-Guide---Part-18
Size: 31912 KB
Views: 1815
|
/MP4-Videos/The-Complete-Sex-Guide---Part-19.mp4)
|
The-Complete-Sex-Guide---Part-19
Size: 31912 KB
Views: 1815
|
/MP4-Videos/The-Complete-Sex-Guide---Part-2.mp4)
|
The-Complete-Sex-Guide---Part-2
Size: 31912 KB
Views: 1815
|
Page 1 of 3